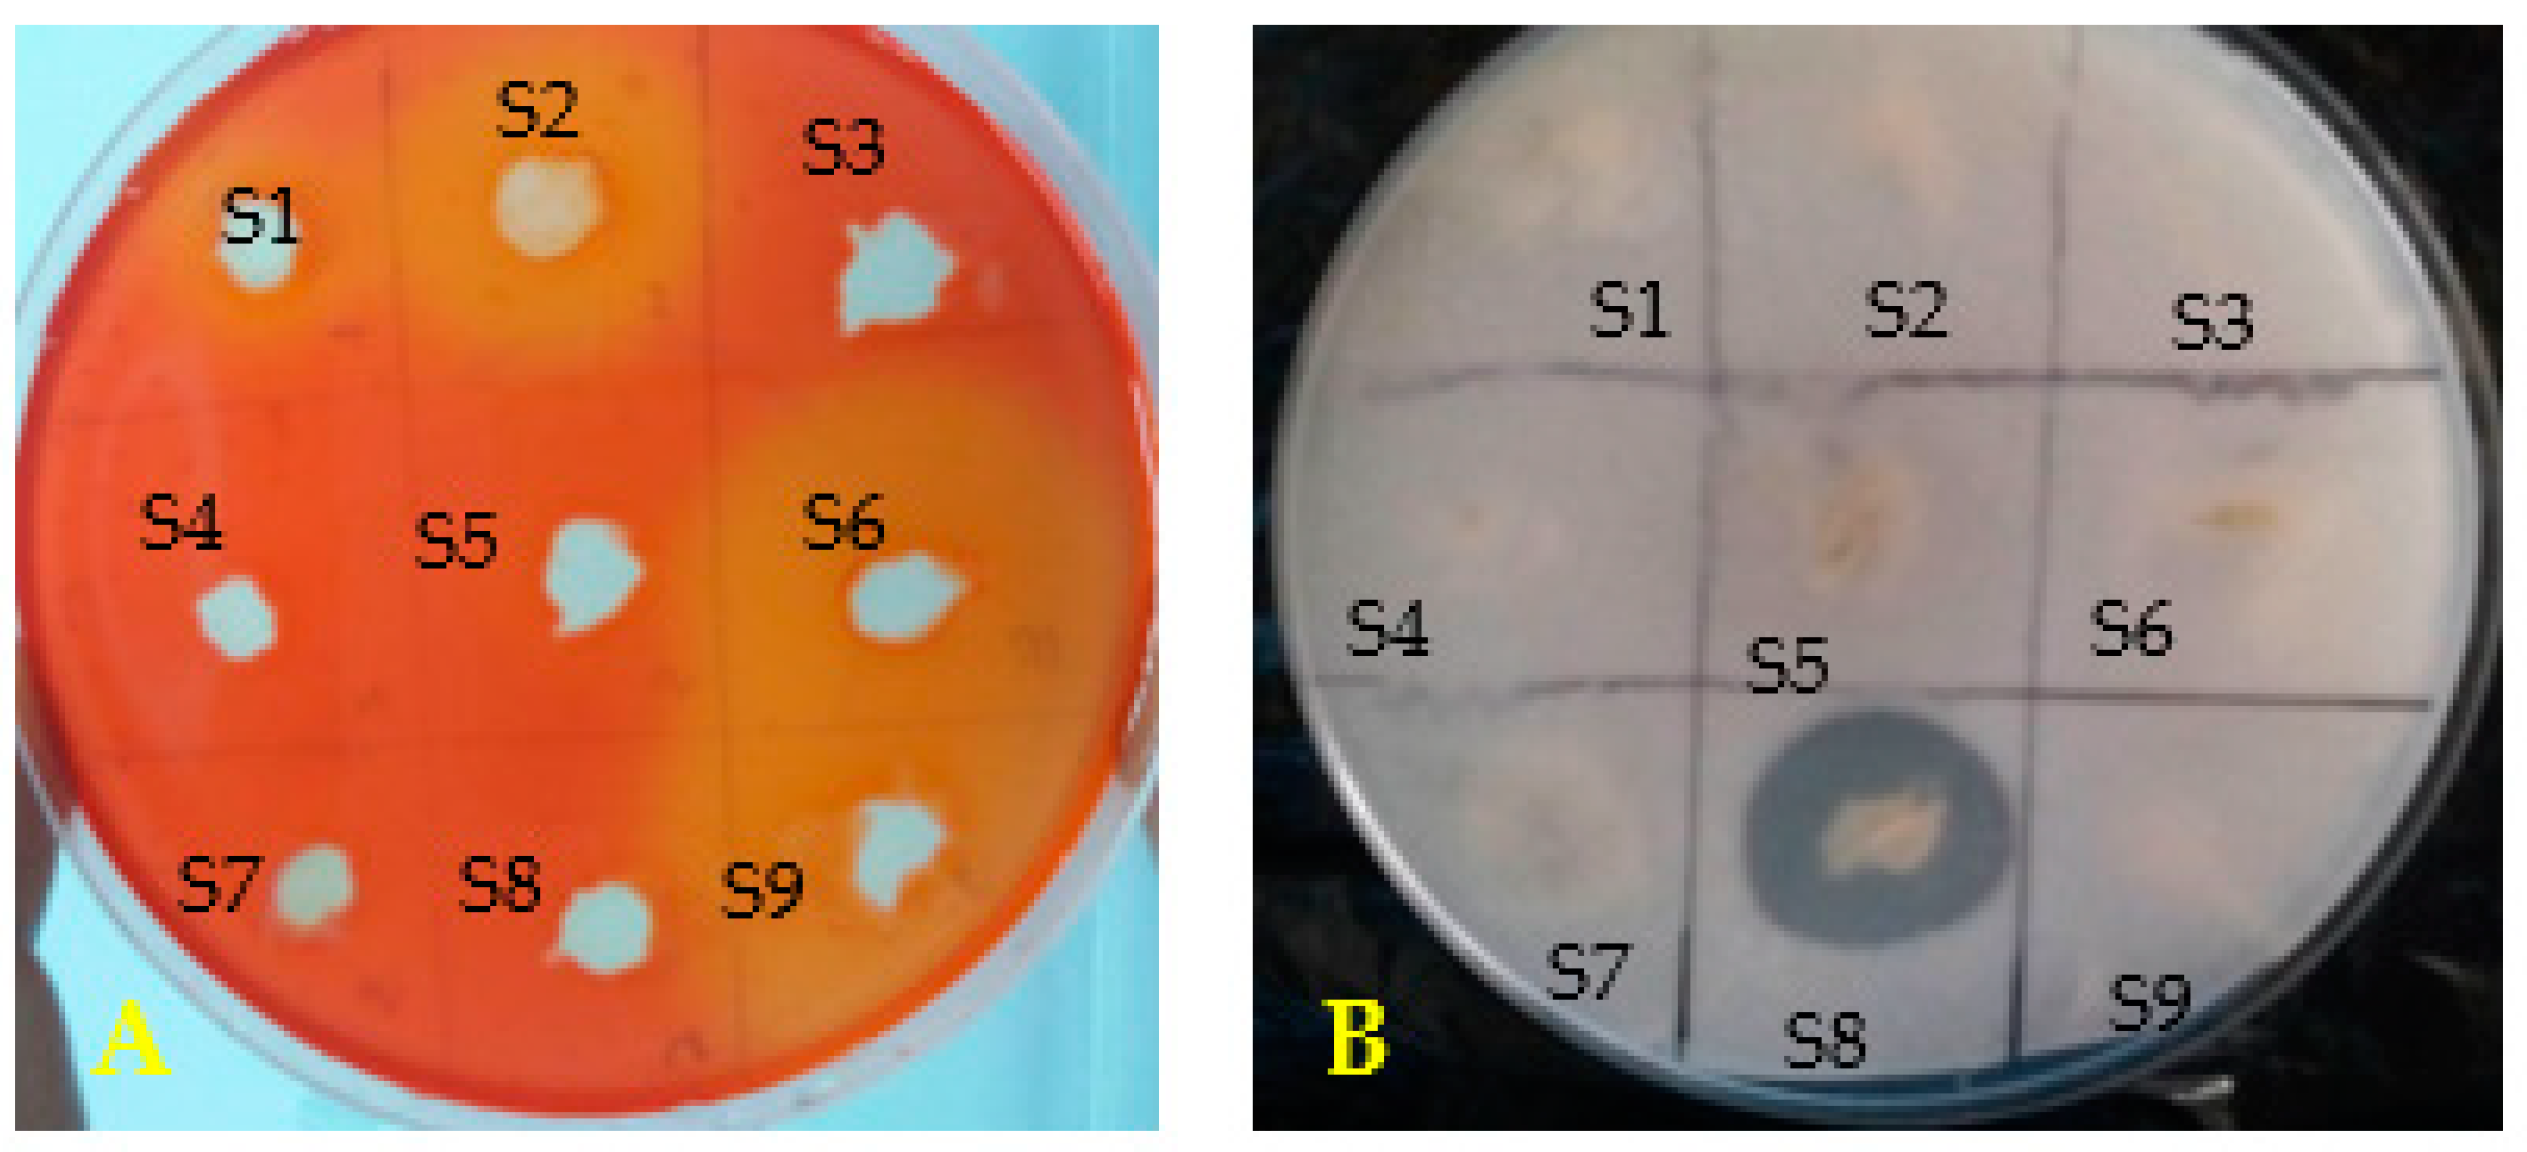
Microorganisms 11 01165 g002

Biocontrol Potential of Some Rhizospheric Soil Bacterial Strains against Fusarium culmorum and Subsequent Effect on Growth of Two Tunisian Wheat Cultivars
Abstract
1. Introduction
2. Materials and Methods
2.1. Antagonistic Activity of Bacterial Isolates In Vitro against Fungal Strains
2.2. PGP Traits of Bacterial Strains
2.2.1. Phosphate Solubilization Assay
2.2.2. Nitrogen Fixation
2.2.3. Indole-3-Acetic-Acid Production
2.2.4. Ammonia Production
2.2.5. Cellulase Detection
2.2.6. Siderophore Assay
2.3. Identification of Selected Bacterial Isolates
2.4. PGPR and Protection of Wheat Plants against F. culmorum by Selected Bacterial Strains (S6 and S8)
2.4.1. Wheat Inoculation by Selected Bacterial Strains and Plant Growth Promotion
2.4.2. Wheat Plants Inoculations with Selected Bacterial Strains and F. culmorum and Disease Assessment
2.5. Extraction and Quantification of Phenol and Chlorophyll
2.6. Statistical Analysis
3. Results
3.1. Bacterial Isolates Antagonism against Fusarium culmorum and Their Plant Growth-Promoting Characteristics
3.2. Characterization and Identification of Isolates S6 and S8
3.3. Plant Growth Promotion Effect of Selected Bacterial Strains on Two Wheat Cultivars (CV Bouanene and CV Hydra)
3.4. Biocontrol of F. culmorum by Two Selected Bacterial Strains
4. Discussion
5. Conclusions
Author Contributions
Funding
Data Availability Statement
Conflicts of Interest
References
- Khemir, E.; Chekali, S.; Moretti, A.; Gharbi, M.S.; Allagui, M.B.; Gargouri, S. Impacts of previous crops on inoculum of Fusarium culmorum in soil, and development of foot and root rot of durum wheat in Tunisia. Phytopathol. Mediterr. 2020, 59, 187–201. [Google Scholar] [CrossRef]
- Mondani, L.; Chiusa, G.; Battilani, P. Chemical and biological control of Fusarium species involved in garlic dry rot at early crop stages. Eur. J. Plant Pathol. 2021, 160, 575–587. [Google Scholar] [CrossRef]
- Ponomarenko, A.; Goodwin, S.B.; Kema, G.H.J. Septoria tritici blotch (STB) of wheat. Plant Health Instr. 2011, 1–7. [Google Scholar] [CrossRef]
- Miller, S.A.; Ferreira, J.P.; LeJeune, J.T. Antimicrobial Use and Resistance in Plant Agriculture: A One Health Perspective. Agriculture 2022, 12, 289. [Google Scholar] [CrossRef]
- Köhl, J.; Kolnaar, R.; Ravensberg, W.J. Mode of Action of Microbial Biological Control Agents Against Plant Diseases: Relevance Beyond Efficacy. Front. Plant Sci. 2019, 10, 845. [Google Scholar] [CrossRef] [PubMed]
- Sadiqi, S.; Hamza, M.; Ali, F.; Alam, S.; Shakeela, Q.; Ahmed, S.; Ayaz, A.; Ali, S.; Saqib, S.; Ullah, F.; et al. Molecular Characterization of Bacterial Isolates from Soil Samples and Evaluation of their Antibacterial Potential against MDRS. Molecules 2022, 27, 6281. [Google Scholar] [CrossRef] [PubMed]
- Vacheron, J.; Desbrosses, G.; Bouffaud, M.L.; Touraine, B.; Moënne-Loccoz, Y.; Muller, D.; Legendre, L.; Wisniewski-Dyé, F.; Prigent-Combaret, C. Plant growth-promoting rhizobacteria and root system functioning. Front. Plant Sci. 2013, 4, 356. [Google Scholar] [CrossRef]
- Ortiz-Castro, R.; Campos-García, J.; López-Bucio, J. Pseudomonas putida and Pseudomonas fluorescens Influence Arabidopsis Root System Architecture Through an Auxin Response Mediated by Bioactive Cyclodipeptides. J. Plant Growth Regul. 2020, 39, 254–265. [Google Scholar] [CrossRef]
- Tian, Y.; Zhang, D.; Cai, P.; Lin, H.; Ying, H.; Hu, Q.N.; Wu, A. Elimination of Fusarium mycotoxin deoxynivalenol (DON) via microbial and enzymatic strategies: Current status and future perspectives. Trends Food Sci. Technol. 2022, 124, 96–107. [Google Scholar] [CrossRef]
- Hemissi, I.; Mabrouk, Y.; Mejri, S.; Saidi, M.; Sifi, B. Enhanced Defence Responses of Chickpea Plants Against Rhizoctonia solani by Pre-Inoculation with Rhizobia. J. Phytopathol. 2013, 161, 412–418. [Google Scholar] [CrossRef]
- Travers, R.S.; Martin, P.A.W.; Reichelderfer, C.F. Selective process for efficient isolation of soil Bacillus sp. Appl. Environ. Microbiol. 1987, 53, 1263–1266. [Google Scholar] [CrossRef] [PubMed]
- Reynaldi, F.J.; De Giusti, M.R.; Alippi, A.M. Inhibition of the growth of Ascosphaera apis by Bacillus and Paenibacillus strains isolated from honey. Rev Argent Microbiol. 2004, 36, 52–55. [Google Scholar] [PubMed]
- Jorquera, M.A.; Hernández, M.T.; Rengel, Z.; Marschner, P.; de la Luz Mora, M. Isolation of culturable phosphobacteria with both phytate-mineralization and phosphate-solubilization activity from the rhizosphere of plants grown in a volcanic soil. Biol. Fertil. Soils. 2008, 44, 1025–1034. [Google Scholar] [CrossRef]
- Bae, H.D.; Yanke, L.J.; Cheng, K.J.; Selinger, L.B. A novel staining method for detecting phytase activity. J. Microbiol. Methods. 1999, 39, 17–22. [Google Scholar] [CrossRef]
- Grobelak, A.; Napora, A.; Kacprzak, M. Using plant growth-promoting rhizobacteria (PGPR) to improve plant growth. Ecol. Eng. 2015, 84, 22–28. [Google Scholar] [CrossRef]
- Patten, C.L.; Glick, B.R. Role of Pseudomonas putida Indole acetic Acid in Development of the Host Plant Root System. Appl. Environ. Microbiol. 2002, 68, 3795–3801. [Google Scholar] [CrossRef]
- Abdelwahed, S.; Trabelsi, E.; Saadouli, I.; Kouidhi, S.; Masmoudi, A.S.; Cherif, A.; Mnif, W.; Mosbah, A. A new pioneer colorimetric micro-plate method for the estimation of ammonia production by plant growth promoting rhizobacteria (PGPR). Main Group Chem. 2022, 21, 55–68. [Google Scholar] [CrossRef]
- Kasana, R.C.; Salwan, R.; Dhar, H.; Dutt, S.; Gulati, A. A Rapid and Easy Method for the Detection of Microbial Cellulases on Agar Plates Using Gram’s Iodine. Curr. Microbiol. 2008, 57, 503–507. [Google Scholar] [CrossRef]
- Louden, B.C.; Haarmann, D.; Lynne, A.M. Use of Blue Agar CAS Assay for Siderophore Detection. J. Microbiol. Biol. Educ. 2011, 12, 51–53. [Google Scholar] [CrossRef]
- Arora, N.K.; Verma, M. Modified microplate method for rapid and efficient estimation of siderophore produced by bacteria. 3 Biotech. 2017, 7, 381. [Google Scholar] [CrossRef]
- Patel, P.R.; Shaikh, S.S.; Sayyed, R.Z. Modified chrome azurol S method for detection and estimation of siderophores having affinity for metal ions other than iron. Environ. Sustain. 2018, 1, 81–87. [Google Scholar] [CrossRef]
- Payne, S.M. Iron acquisition in microbial pathogenesis. Trends Microbiol. 1993, 1, 66–69. [Google Scholar] [CrossRef] [PubMed]
- Abid, S.; Farid, A.; Abid, R.; Rehman, M.U.; Alsanie, W.F.; Alhomrani, M.; Alamri, A.S.; Asdaq, S.M.B.; Hefft, D.I.; Saqib, S.; et al. Identification, Biochemical Characterization, and Safety Attributes of Locally Isolated Lactobacillus fermentum from Bubalus bubalis (buffalo) Milk as a Probiotic. Microorganisms 2022, 10, 954. [Google Scholar] [CrossRef] [PubMed]
- Broughton, W.J.; Dilworth, M.J. Control of leghaemoglobin synthesis in snake beans. Biochem. J. 1971, 125, 1075–1080. [Google Scholar] [CrossRef]
- Singleton, V.L.; Rossi, J.A. Colorimetry of total phenolics with phosphomolybdic-phosphotungstic acid reagents. Am. J. Enol. Vitic. 1965, 16, 144–158. [Google Scholar]
- Vernon, L.P. Spectrophotometric Determination of Chlorophylls and Pheophytins in Plant Extracts. Anal. Chem. 1960, 32, 1144–1150. [Google Scholar] [CrossRef]
- Pandit, M.A.; Kumar, J.; Gulati, S.; Bhandari, N.; Mehta, P.; Katyal, R.; Rawat, C.D.; Mishra, V.; Kaur, J. Major Biological Control Strategies for Plant Pathogens. Pathogens 2022, 11, 273. [Google Scholar] [CrossRef] [PubMed]
- Esikova, T.Z.; Anokhina, T.O.; Abashina, T.N.; Suzina, N.E.; Solyanikova, I.P. Characterization of Soil Bacteria with Potential to Degrade Benzoate and Antagonistic to Fungal and Bacterial Phytopathogens. Microorganisms. 2021, 9, 755. [Google Scholar] [CrossRef] [PubMed]
- Yi, Y.; Luan, P.; Wang, K.; Li, G.; Yin, Y.; Yang, Y.; Zhang, Q.; Liu, Y. Antifungal Activity and Plant Growth-Promoting Properties of Bacillus mojovensis B1302 against Rhizoctonia cerealis. Microorganisms 2022, 10, 1682. [Google Scholar] [CrossRef]
- Kim, M.J.; Shim, C.K.; Park, J. Control Efficacy of Bacillus velezensis AFB2-2 against Potato Late Blight Caused by Phytophthora infestans in Organic Potato Cultivation. Plant Pathol. J. 2021, 37, 580. [Google Scholar] [CrossRef]
- Li, Y.; Heloir, M.C.; Zhang, X.; Geissler, M.; Trouvelot, S.; Jacquens, L.; Henkel, M.; Su, X.; Fang, X.; Wang, Q.; et al. Surfactin and fengycin contribute to the protection of a Bacillus subtilis strain against grape downy mildew by both direct effect and defence stimulation. Mol. Plant Pathol. 2019, 20, 1037–1050. [Google Scholar] [CrossRef] [PubMed]
- Su, Y.; Liu, C.; Fang, H.; Zhang, D. Bacillus subtilis: A universal cell factory for industry, agriculture, biomaterials and medicine. Microb. Cell Fact. 2020, 19, 173. [Google Scholar] [CrossRef] [PubMed]
- Kim, Y.S.; Lee, Y.; Cheon, W.; Park, J.; Kwon, H.T.; Balaraju, K.; Kim, J.; Yoon, Y.J.; Jeon, Y. Characterization of Bacillus velezensis AK-0 as a biocontrol agent against apple bitter rot caused by Colletotrichum gloeosporioides. Sci. Rep. 2021, 11, 626. [Google Scholar] [CrossRef] [PubMed]
- Dal Cortivo, C.; Ferrari, M.; Visioli, G.; Lauro, M.; Fornasier, F.; Barion, G.; Panozzo, A.; Vamerali, T. Effects of seed-applied biofertilizers on rhizosphere biodiversity and growth of common wheat (Triticum aestivum L.) in the field. Front. Plant Sci. 2020, 11, 72. [Google Scholar] [CrossRef]
- Xiao, X.; Zhu, Y.; Gao, C.; Zhang, Y.; Gao, Y.; Zhao, Y. Microbial inoculations improved rice yields by altering the presence of soil rare bacteria. Microbiol. Res. 2022, 254, 126910. [Google Scholar] [CrossRef]
- Anušauskas, J.; Steponavičius, D.; Romaneckas, K.; Lekavičienė, K.; Zaleckas, E.; Sendžikienė, E. The Influence of Bacteria-Inoculated Mineral Fertilizer on the Productivity and Profitability of Spring Barley Cultivation. Plants 2023, 12, 1227. [Google Scholar] [CrossRef]
- Saeed, Q.; Xiukang, W.; Haider, F.U.; Kučerik, J.; Mumtaz, M.Z.; Holatko, J.; Naseem, M.; Kintl, A.; Ejaz, M.; Naveed, M.; et al. Rhizosphere Bacteria in Plant Growth Promotion, Biocontrol, and Bioremediation of Contaminated Sites: A Comprehensive Review of Effects and Mechanisms. Int. J. Mol. Sci. 2021, 22, 10529. [Google Scholar] [CrossRef]
- Çıg, F.; Sönmez, F.; Nadeem, M.A.; Sabagh, A.E. Effect of Biochar and PGPR on the Growth and Nutrients Content of Einkorn Wheat (Triticum monococcum L.) and Post-Harvest Soil Properties. Agronomy 2021, 11, 2418. [Google Scholar] [CrossRef]
- Saber, Z.; Pirdashti, H.; Esmaeili, M.; Abbasian, A.; Heidarzadeh, A. Response of Wheat Growth Parameters to Co-Inoculation of Plant Growth Promoting Rhizobacteria (PGPR) and Different Levels of Inorganic Nitrogen and Phosphorus. World Appl. Sci. J. 2012, 16, 213–219. [Google Scholar]
- Shi, T.Q.; Peng, H.; Zeng, S.Y.; Ji, R.Y.; Shi, K.; Huang, H.; Ji, X.J. Microbial production of plant hormones: Opportunities and challenges. Bioengineered. 2017, 8, 124–128. [Google Scholar] [CrossRef]
- Kudoyarova, G.; Arkhipova, T.; Korshunova, T.; Bakaeva, M.; Loginov, O.; Dodd, I.C. Phytohormone Mediation of Interactions Between Plants and Non-Symbiotic Growth Promoting Bacteria Under Edaphic Stresses. Front. Plant Sci. 2019, 10, 1368. [Google Scholar] [CrossRef]
- Mishra, M.; Kumar, U.; Mishra, P.K.; Prakash, V. Efficiency of plant growth promoting rhizobacteria for the enhancement of Cicer arietinum L growth and germination under salinity. Adv. Biol. Res. 2010, 4, 92–96. [Google Scholar]
- Pathma, J.; Kennedy, R.K.; Sakthivel, N. Mechanisms of fluorescent pseudomonads that mediate biological control of phytopathogens and plant growth promotion of crop plants. In Bacteria in Agrobiology: Plant Growth Responses; Maheshwari, D.K., Ed.; Springer: Berlin/Heidelberg, Germany, 2011; pp. 77–105. [Google Scholar]
- Hayat, R.; Ali, S.; Amara, U.; Khalid, R.; Ahmed, I. Soil beneficial bacteria and their role in plant growth promotion: A review. Ann. Microbiol. 2010, 60, 579–598. [Google Scholar] [CrossRef]
- Zhang, S.; Deng, Z.; Borham, A.; Ma, Y.; Wang, Y.; Hu, J.; Wang, J.; Bohu, T. Significance of Soil Siderophore-Producing Bacteria in Evaluation and Elevation of Crop Yield. Horticulturae 2023, 9, 370. [Google Scholar] [CrossRef]
- Ghazy, N.; El-Nahrawy, S. Siderophore production by Bacillus subtilis MF497446 and Pseudomonas koreensis MG209738 and their efficacy in controlling Cephalosporium maydis in maize plant. Arch. Microbiol. 2021, 203, 1195–1209. [Google Scholar] [CrossRef] [PubMed]
- Bholay, A.D.; Borkhataria, B.V.; Jadhav, P.U.; Palekar, K.S.; Dhalkari, M.V.; Nalawade, P.M. Bacterial Lignin Peroxidase: A Tool for Biobleaching and Biodegradation of Industrial Effluents Univers. J. Environ. Res. Technol. 2012, 2, 58–64. [Google Scholar]
- Reetha, S.; Selvakumar, G.; Bhuvaneswari, G.; Thamizhiniyan, P.; Ravimycin, T. Screening of cellulase and pectinase by using Pseudomonas fluorescens and Bacillus subtilis. Int. Let. Nat. Sci. 2014, 8, 75–80. [Google Scholar] [CrossRef]
- Sebihi, F.Z.; Benguedouar, A.; Benhizia, Y.; Sanchez, J.; Gallego, E. Evaluation of multi-trait plant growth promoting Pseudomonas fluorescens isolated from Constantine Wheat rhizosphere soil (Algeria) and screening their antifungal activity against two species of Fusarium. Adv. Environ. Biol. 2016, 10, 102–116. [Google Scholar]
- Park, S.; Kim, A.L.; Hong, Y.K.; Shin, J.H.; Joo, S.H. A highly efficient auxin-producing bacterial strain and its effect on plant growth. J. Genet. Eng. Biotechnol. 2021, 19, 179. [Google Scholar] [CrossRef]
- Mabrouk, Y.; Mejri, S.; Belhadj, O. Biochemical mechanisms of induced resistance by rhizobial lipopolysaccharide in pea against crenate broomrape. Braz. J. Bot. 2016, 39, 107–114. [Google Scholar] [CrossRef]
- Gregorová, Z.; Kováčik, J.; Klejdus, B.; Maglovski, M.; Kuna, R.; Hauptvogel, P.; Matušíková, I. Drought-Induced Responses of Physiology, Metabolites, and PR Proteins in Triticum aestivum. J. Agric. Food Chem. 2015, 63, 8125–8133. [Google Scholar] [CrossRef] [PubMed]
- Garcia-Guetierrez, L.; Romero, D.; Zeriouh, H.; Cazorla, F.M.; Tores, J.A.; Devicente, A.; Garcia, P. Isolation and selection of plant growth promoting rhizobacteria as inducers of systemic resistance in melon. Plant Soil. 2012, 358, 201–212. [Google Scholar] [CrossRef]

| Inhibition of Fungal Growth (%) | ||||
|---|---|---|---|---|
| Strain No | Fusarium graminearum | Verticilium dahlia | Phytophtora sp. | Fusarium culmorum |
| S1 | 75.73 ± 0.67 a | 71.25 ± 2.17 b | 72.87 ± 2.93 a | 87.5 ± 1.78 a |
| S2 | 0 | 45.00 ± 2.5 d | 0 | 80 ± 2.14 b |
| S3 | 59.69 ± 2.42 bc | 0 | 48.84 ± 1.16 d | 57.5 ± 1.21 e |
| S4 | 51.55 ± 1.78 c | 59.58 ± 0.72 c | 0 | 65 ± 0.98 d |
| S5 | 65.50 ± 2.42 ab | 78.33 ± 0,72 a | 71.32 ± 5.37 a | 62.5 ± 1.25 de |
| S6 | 64.19 ± 1.34 b | 77.08 ± 2.6 a | 64.34 ± 3.74 b | 72.5 ± 2.21 c |
| S7 | 71.71 ± 1.78 a | 67.50 ± 4.33 b | 62.79 ± 2.53 b | 77.5 ± 1.98 bc |
| S8 | 68.60 ± 3.08 a | 78.33 ± 0.72 a | 63.57 ± 3.36 b | 84.5 ± 1.54 ab |
| S9 | 61.24 ± 6.71 b | 75.83 ± 3.82 a | 68.99 ± 1.34 ab | 14.5 ± 0.25 f |
| Strains Reference | NH3 (mg/mL) | IAA (mg/mL) | Solubilization of Inorganic Phosphate (mg/mL) | Mineralization of Organic Phosphate (mg/mL) | Nitrogen Fixation | Siderophore Production | Cellulase |
|---|---|---|---|---|---|---|---|
| S1 | 0.16 ± 0.01 | 0.002 ± 0.002 | 0 | 0 | - | - | - |
| S2 | 0.11 ± 0.01 | 0 | 0 | 0 | + | - | - |
| S3 | 0.15 ± 0.01 | 0.007 ± 0.003 | 0.14 ± 0.04 | 0 | + | - | - |
| S4 | 0.3 ± 0.07 | 0 | 0 | 0 | + | - | - |
| S5 | 0.18 ± 0.03 | 0.007 ± 0.004 | 0.04 ± 0.002 | 0 | + | - | - |
| S6 | 0.69 ± 0.05 | 0.21 ± 0.01 | 0.14 ± 0.02 | 0 | + | + | + |
| S7 | 0.25 ± 0.04 | 0 | 0.06 ± 0.01 | 0 | - | - | + |
| S8 | 0.39 ± 0.02 | 0.002 ± 0.001 | 0.15 ± 0.05 | 0.003 ± 0.02 | + | + | - |
| S9 | 0.02 ± 0.01 | 0 | 0 | 0 | - | - | - |
| Bacterial Isolates | Classification |
|---|---|
| S6 | B. subtilis: 168 (NR_102783.1) |
| S8 | B. amyloliquefaciens: 9 MPA 1034 (NR_117946.1) |
Disclaimer/Publisher’s Note: The statements, opinions and data contained in all publications are solely those of the individual author(s) and contributor(s) and not of MDPI and/or the editor(s). MDPI and/or the editor(s) disclaim responsibility for any injury to people or property resulting from any ideas, methods, instructions or products referred to in the content. |
© 2023 by the authors. Licensee MDPI, Basel, Switzerland. This article is an open access article distributed under the terms and conditions of the Creative Commons Attribution (CC BY) license (https://creativecommons.org/licenses/by/4.0/).
Share and Cite
Kouki, H.; Souihi, M.; Saadouli, I.; Balti, S.; Ayed, A.; Majdoub, N.; Mosbah, A.; Amri, I.; Mabrouk, Y. Biocontrol Potential of Some Rhizospheric Soil Bacterial Strains against Fusarium culmorum and Subsequent Effect on Growth of Two Tunisian Wheat Cultivars. Microorganisms 2023, 11, 1165. https://doi.org/10.3390/microorganisms11051165
Kouki H, Souihi M, Saadouli I, Balti S, Ayed A, Majdoub N, Mosbah A, Amri I, Mabrouk Y. Biocontrol Potential of Some Rhizospheric Soil Bacterial Strains against Fusarium culmorum and Subsequent Effect on Growth of Two Tunisian Wheat Cultivars. Microorganisms. 2023; 11(5):1165. https://doi.org/10.3390/microorganisms11051165
Chicago/Turabian StyleKouki, Habiba, Mouna Souihi, Ilhem Saadouli, Sabrine Balti, Amira Ayed, Nihed Majdoub, Amor Mosbah, Ismail Amri, and Yassine Mabrouk. 2023. "Biocontrol Potential of Some Rhizospheric Soil Bacterial Strains against Fusarium culmorum and Subsequent Effect on Growth of Two Tunisian Wheat Cultivars" Microorganisms 11, no. 5: 1165. https://doi.org/10.3390/microorganisms11051165
APA StyleKouki, H., Souihi, M., Saadouli, I., Balti, S., Ayed, A., Majdoub, N., Mosbah, A., Amri, I., & Mabrouk, Y. (2023). Biocontrol Potential of Some Rhizospheric Soil Bacterial Strains against Fusarium culmorum and Subsequent Effect on Growth of Two Tunisian Wheat Cultivars. Microorganisms, 11(5), 1165. https://doi.org/10.3390/microorganisms11051165

